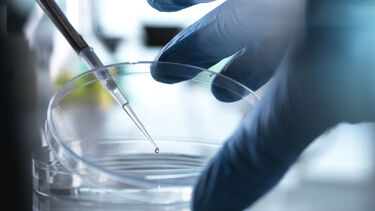
Scientist using petri dish

Harnessing advances in neuroscience
Each year hundreds of millions of people die from over a thousand neurological disorders for which we have yet to find a cure. We are harnessing advances in neuroscience to improve the lives of patients and their families.
Discover and diagnose

We are unravelling the mysteries of the nervous system
Our research is providing a better understanding of the complexity of the nervous system. We unite scientists, clinicians and engineers to discover the causes of neurological conditions so that we can improve the lives of people with dementia, motor neurone disease, autism, Parkinson’s disease, sensory disorders, chronic pain and the after effects of stroke.
Understand and transform

We are improving quality of life
Our research is informed by close collaboration with patient groups to pioneer new technologies and treatments. We are supporting patients to manage their symptoms and minimise disability. Researchers are developing tools that explain conditions and help patients make informed choices about their care.
Translate and restore

We are advancing therapies
Our collaborations with Sheffield Teaching Hospitals NHS Foundation Trust, the NIHR Biomedical Research Centre and the pharmaceutical industry ensure we can translate basic neuroscience research into experimental medicine studies. Our research investigates therapies tailored to individual patients for better results and uses computational modelling to improve diagnosis, prognosis and treatment.